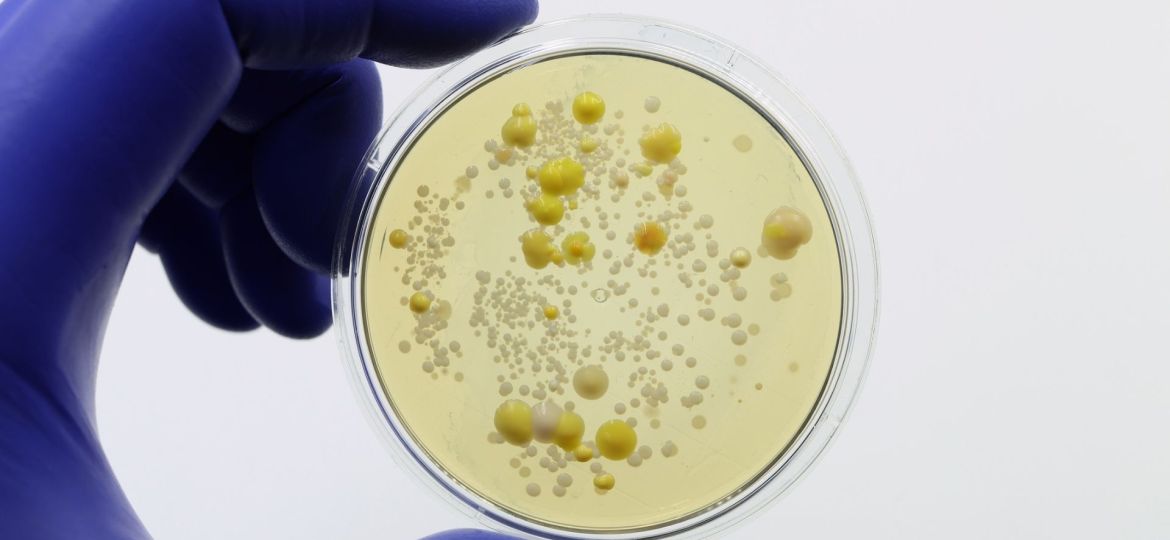
bactéria

As investigadoras do Centro de Neurociências e Biologia Celular da Universidade de Coimbra (CNC-UC), Ana Eulálio e Cristina Márquez, vão ser apoiadas pela Fundação ”la Caixa”, no âmbito do concurso de Investigação em Saúde. O objetivoé estudar comportamento social e resistência de uma bactéria.
Os projetos vão investigar a sobrevivência intracelular e resistência microbiana da bactéria Staphylococcus aureus (um dos principais agentes responsáveis por infeções adquiridas em meio hospitalar e comunitário) e os mecanismos cerebrais do comportamento social e da empatia, e vão receber, em conjunto, cerca de 1,5 milhões de euros.
A investigação de Ana Eulálio, líder do grupo de investigação RNA & Infeção do CNC-UC, vai estudar a sobrevivência intracelular e a resistência aos antibióticos da bactéria Staphylococcus aureus.
“O objetivo deste projeto é identificar os fatores genéticos que permitem ao Staphylococcus aureus invadir, sobreviver e replicar-se em diferentes tipos de células hospedeiras”, explica a investigadora principal do CNC-UC. O projeto visa melhorar as estratégias terapêuticas contra as infeções provocadas por este patógeno, e pode vir a contribuir para uma mudança de paradigma no tratamento das infeções por Staphylococcus aureus. O projeto “Estudo da sobrevivência intracelular e da resistência aos antibióticos de Staphylococcus aureus” é financiado com 473 902,70 euros.
O projeto de Cristina Márquez, líder do grupo de investigação Circuitos Neuronais do Comportamento Social do CNC-UC, procura descodificar os mecanismos cerebrais subjacentes à empatia e ao comportamento social, isto é, descobrir como é que o cérebro compreende e responde às emoções das outras pessoas.
“Apesar da sua importância, os mecanismos cerebrais responsáveis pelo processamento da informação social continuam em grande parte por desvendar”, explica a investigadora principal do CNC-UC. Compreender como o cérebro percebe os estados de recompensa dos outros pode abrir caminho a tratamentos para perturbações como a depressão e o autismo.
O projeto resulta de um consórcio estabelecido com o investigador Alexandre Charlet, do Instituto de Neurociência Celular e Integrativa (Institute for Cellular and Integrative Neuroscience). O projeto “Circuitos neurais subjacentes à perceção das emoções dos outros” é financiado em 999 930 euros.
Na oitava edição do concurso promovido pela Fundação ”la Caixa”, foram apresentadas 714 propostas de investigação básica, clínica e translacional. Os projetos selecionados em 2025 são liderados por 25 centros de investigação, universidades e hospitais espanhóis, e nove portugueses.
O concurso conta com a colaboração da Fundação para a Ciência e a Tecnologia (FCT), que destina 1,8 milhões de euros para financiar três dos nove projetos portugueses premiados nesta edição.
Crédito imagem: iStock















